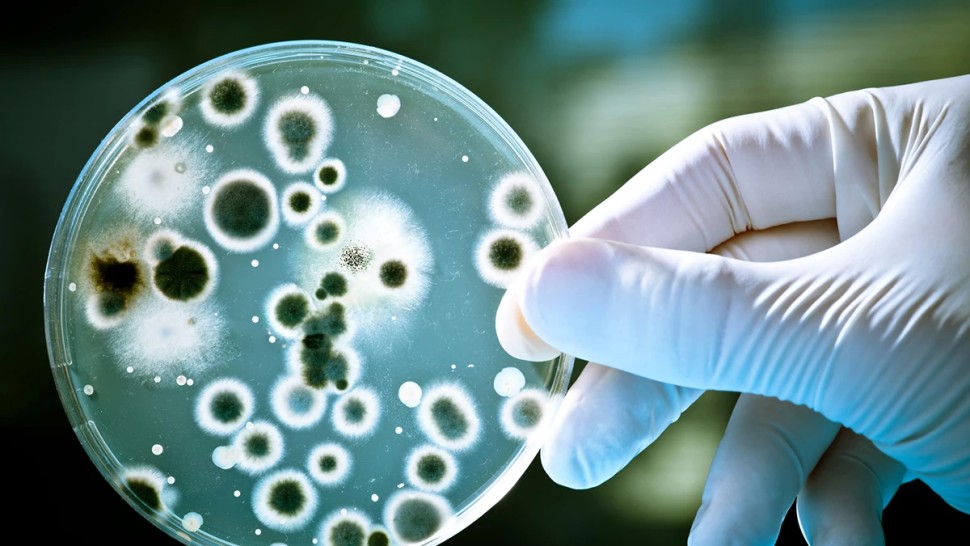
A apărut un nou antibiotic experimental Eficient împotriva bacteriilor rezistente la multiple medicamente spun cercetătorii britanici

A apărut un nou antibiotic experimental! Eficient împotriva bacteriilor rezistente la multiple medicamente, spun cercetătorii britanici
O descoperire de răsunet a fost făcută de cercetătorii britanici, după ce aceștia au anunțat că un nou antibiotic sintetic a demonstrat o eficienţă ridicată în laborator împotriva unor bacterii rezistente la multiple medicamente, incluse de Organizaţia Mondială a Sănătăţii (OMS) în lista cu agenţi patogeni prioritari.
A apărut un nou antibiotic experimental
În testele de laborator, noul antibiotic a depăşit în eficienţă mai multe antibiotice aprobate şi utilizate în prezent, cum sunt vancomicină, daptomicină, linezolid, levofloxacină şi cefotaxim.
Cercetătorii au creat noul antibiotic pornind de la teixobactină, o moleculă naturală produsă de bacteriile din sol pentru a elimina microorganismele concurente. Prin sinteză, echipa de cercetare a optimizat structura moleculei pentru a fi mai eficientă şi mai uşor de produs la scară largă.
Studiul, publicat în Journal of Medicinal Chemistry, arată că antibioticul, numit Novltex a reuşit să elimine bacterii extrem de periculoase, inclusiv Staphylococcus aureus (Stafilococul auriu) rezistent la meticilină (MRSA), la doze foarte mici.
Eficient împotriva bacteriilor rezistente la multiple medicamente, spun cercetătorii britanici
Spre deosebire de antibioticele clasice, noul medicament acţionează asupra unei molecule-cheie implicate în formarea peretelui celular bacterian, numită lipid II. Această moleculă are un rol vital în menţinerea structurii şi protecţiei bacteriei şi, spre deosebire de alte ţinte bacteriene, nu suferă modificări genetice (mutaţii). Această caracteristică reduce semnificativ riscul ca bacteriile să dezvolte rezistenţă la tratament, o problemă majoră în medicină.
„Acest antibiotic reprezintă un progres semnificativ în lupta împotriva rezistenţei la antimicrobiene (RAM). Deşi sunt necesare mai multe teste înainte ca acest medicament să fie disponibil pentru pacienţi, rezultatele noastre arată că sunt posibile soluţii durabile şi practice pentru combaterea rezistenţei antimicrobiene”, a declarat, joi, coordonatorul studiului, dr. Ishwar Singh, de la Universitatea din Liverpool, citat într-un comunicat.
Rezistenţa la antibiotice este considerată de OMS una dintre cele mai grave ameninţări la adresa sănătăţii publice la nivel mondial. Superbacteriile rezistente la multiple medicamente cauzează anual milioane de infecţii şi decese la nivel mondial, iar opţiunile terapeutice eficiente sunt din ce în ce mai limitate.
Noul antibiotic experimental se află încă în faza de cercetare preclinică şi nu este aprobat pentru utilizare, însă deschide noi perspective pentru dezvoltarea unor tratamente capabile să învingă infecţiile rezistente.













